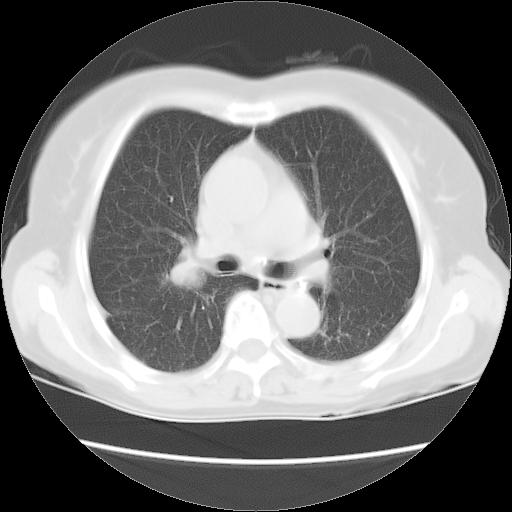
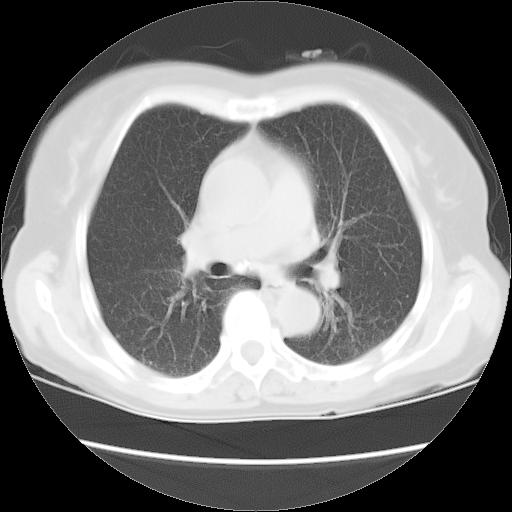

以下是引用卜一在2007-9-18 14:41:00的发言:[br]右肺肿块:毛刺+胸膜凹陷征+供血血管+浅分叶+强化。支持:周围性肺癌 !另:左侧甲状腺腺瘤!
以下是引用卜一在2007-9-18 14:41:00的发言:[br]右肺肿块:毛刺+胸膜凹陷征+供血血管+浅分叶+强化。支持:周围性肺癌 !另:左侧甲状腺腺瘤!
以下是引用夏季在2007-9-18 11:00:00的发言:[br]1。右肺肿块,周围有短毛刺,肺门侧有血管与其相连,胸壁侧有胸膜凹陷征,考虑周围性肺癌 2。左侧甲状腺软组织肿块,内有高密度钙化灶,考虑左侧甲状腺腺瘤。
| 欢迎光临 医影在线 (http://bbs.radida.com/bbs/) | Powered by Discuz! X3.2 |